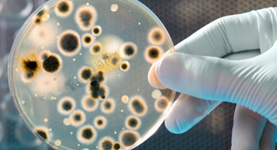

Success Pathways is the place where pathways toward greatness are paved one brick at a time.
We provide four pathways, one topic at a time, that empower you to grow holistically as you march forward to become world-class in what you do, and ultimately attain greatness in your own unique way.
You need our organizational development programs:
- if you would like to establish/re-establish a new organization with a unique corporate culture that advances your mission, protects your vision, aligns with your brand, and is based on what matters the most for you (your core values);
- if your existing culture has become dysfunctional lately or not functioning optimally;
- if you desire your new supervisors, managers, and/or executives to make a smooth transition and excel at their first-time managerial roles, and deliver results quickly;
- if you would like your people to improve their soft skills (people skills) and as a result get along well, create synergy, harmony, and improve their individual and collective performance.
We'll custom design organizational development programs on the following three aspects of your organization:
- Culture,
- Management, and
- Softskills.
Available programs
Below are the available Organizational Development programs you may request.

How to excel as a new supervisor
We offer programs to prepare 1st-time team leaders, project managers, supervisors, and new business owners to make a smooth transition and excel in their first-time leadership roles.
Schedule for a 1 on 1 callHow to lead from the middle and excel right away
We provide programs that equip 1st-time middle leaders to make a successful transition from supervising at the front to mastering leading from the middle successfully.
Schedule for a 1 on 1 call

How to succeed as a new executive
We design programs to empower 1st-time executives to make an effective transition to executive leadership & successfully fulfilling their mandates right away.
Schedule for a 1 on 1 callHow to create a unique corporate culture
We custom design a program that equips founders and shareholders who recently formed a new organization or planning to establish soon to create a unique corporate culture that advances the mission, protects the vision, aligns with the brand, and is based on core values. If you're interested, we can also consult you and involve to reform your culture.
Schedule for a 1 on 1 call
Reform your culture
We deliver a program that empowers your leaders to play their fair share to reform their corporate culture. If you're interested, we can also consult you and involve to reform your culture.
Schedule for a 1 on 1 callSoft skills for organizational competence
We design and deliver stand-alone and cohort soft skills programs to empower professionals, admin staff, and leaders.
Schedule for a 1 on 1 call
How does it work?
We closely work with you to understand your needs and aspirations and design the right program for your people.
Our programs will be delivered based on the latest adult learning principles. There will be:
- Short presentations,
- Role plays,
- Large and small groups, and
- Pairing discussions.
We provide a workbook for each program. If opted, participants will take assessments for some of the topics.
These programs can be delivered as:
- 1- 3 day workshops in a retreat format, or
- A few weeks group coaching style, or
- For up to 6 months in a cohort system.
In the latter case, there will be orientation, participants will get pre-readings and follow-up emails in between sessions, and a graduation in the end.
Do you need transition & transformation programs?
Watch the short video clip that explains some of the organizational development programs we design and deliver.


Stay Connected
Join our community to get updates & empowering resources in our free newsletter.
SIGN UPLet's Talk
Get in touch for answers to any questions and to learn more about the powerful techniques behind Success Pathways products and services.